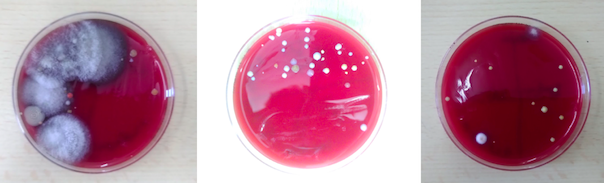

📢 Publicats els llistats d’alumnes i docents seleccionats dins del programa Erasmus+ 2025-26!
04/02/26Ja podeu consultar a la web de l’Erasmus de l’Institut Rocagrossa els diferents documents publicats a la secció de notícies amb els llistats oficials de participants seleccionats per al programa Erasmus+ durant el curs 2025-2026.
📄 Què hi trobareu?
👉 Els llistats d’alumnat i professorat escollits per a les mobilitats d’Erasmus+ d’aquest curs, amb les persones que han estat seleccionades per participar en estades i projectes internacionals.
📌 Els documents inclouen la relació de candidats seleccionats i, si escau, les persones en llista d’espera o reserves, tal com s’ha anat publicant al llarg del procés de selecció que ha tingut lloc des de l’obertura de la convocatòria el passat novembre